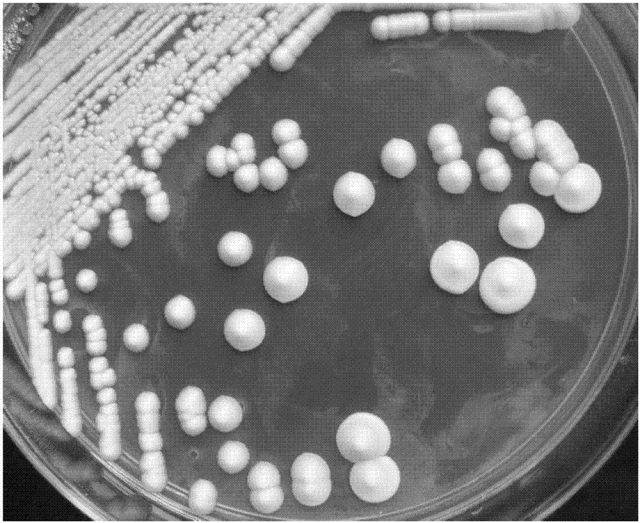

提到酵母,大家都不陌生。
蒸馒头、烤面包,离不开它;酿葡萄酒、做酸奶,也少不了它。但很多人心里都有个疑问:酵母是人造的还是天生的?其实答案很简单,就藏在你脚下的土里。

今天咱们就来一篇纯科普,把酵母的来源彻底聊明白。看完你会发现,这不起眼的小东西,其实早就悄悄住在大自然的各个角落了。
说到底,酵母的来源全在大自然
先说个核心事实:酵母不是人工合成的。它本来就是自然界里的一种单细胞真菌,一直就在我们身边。我们平时用到的各种酵母,追根溯源,全是从大自然里“请”出来的——经过筛选、驯化,成了现在的模样。
酵母的来源主要有三大类,每一种都不难遇见。

天然酵母:大自然自带的“免费发酵库”
这是酵母最原始的家底,也是所有酵母的“老祖宗”。不用人工培育,只要留点心,身边到处都是。
土壤,是酵母的大本营
大多数表层土壤里都有酵母。尤其是那些有机质丰富的土,比如森林里的腐殖土、菜园里的黑土,每克土壤里可能藏着几百甚至上万只酵母。它们靠分解落叶、枯枝活着,还会聚在植物根系附近,默默帮着搞土壤里的碳氮循环。可以说,土壤是大自然最稳定的“酵母储备库”。
植物表面,最容易撞见
你有没有注意过,葡萄、苹果、浆果表皮上那层薄薄的“果粉”?里面全是天然酵母。所以自制葡萄酒不用额外加酵母,光靠果皮上带的就能发酵起来。除了水果,小麦、水稻的外壳,花瓣、叶片上,也都有酵母附着。这是咱们日常生活中最容易接触到的一类。

其他角落,也藏着它们
空气里的灰尘、水汽中,飘着酵母的孢子,虽说浓度不高,但无处不在。蜜蜂、果蝇这些虫子身上也带着酵母,飞到哪里就带到哪里。甚至湖水、潮湿的树皮、石头表面,只要有点糖分、有点潮气,酵母就能活下去。这些地方连起来,就是大自然里一张隐形的“酵母循环网”。
食品用酵母:从大自然里挑出来的“发酵好手”
咱们平时蒸馒头、烤面包、酿酒用的酵母,可不是直接从土里挖来就用的。那是科学家从自然界(比如果皮、土壤)里,挑出那些发酵快、性子稳的野生酵母——最常见的是酿酒酵母——然后纯化、扩繁,做成干酵母、鲜酵母。
它们的任务很专一:快速发酵、拼命产气,让面团蓬起来,让粮食变成酒。菌种单一,效率高,跟食品加工是绝配。
农业用酵母:从自然里筛出来的“土壤帮手”
除了吃的,酵母在农业上也有一席之地。这类酵母同样来自大自然,只是经过了定向筛选和驯化。
农业上用的酵母,大多是从土壤、植物表面挑出来的野生种类,比如假丝酵母、红酵母。人工驯化之后,让它们更能抗逆境、更能转化养分,拿来改良土壤、促进植物生长、防治病害。它们和食品用酵母算同门师兄弟,只是干的活儿不一样罢了。
归根结底,酵母的根在大自然
绕了一大圈,你会发现:
天然酵母就在自然界里自在地循环,是一切酵母的“源头”
食品用酵母、农业用酵母,都是人类从天然酵母里筛选、驯化出来的
它们只是分工不同,骨子里还是那个来自大自然的酵母。
下次你再看到发酵的食物,或者脚下一把肥沃的土,不妨想想——那里头或许就有酵母的影子。它们安安静静地参与着大自然的循环,也默默滋养着我们的生活。